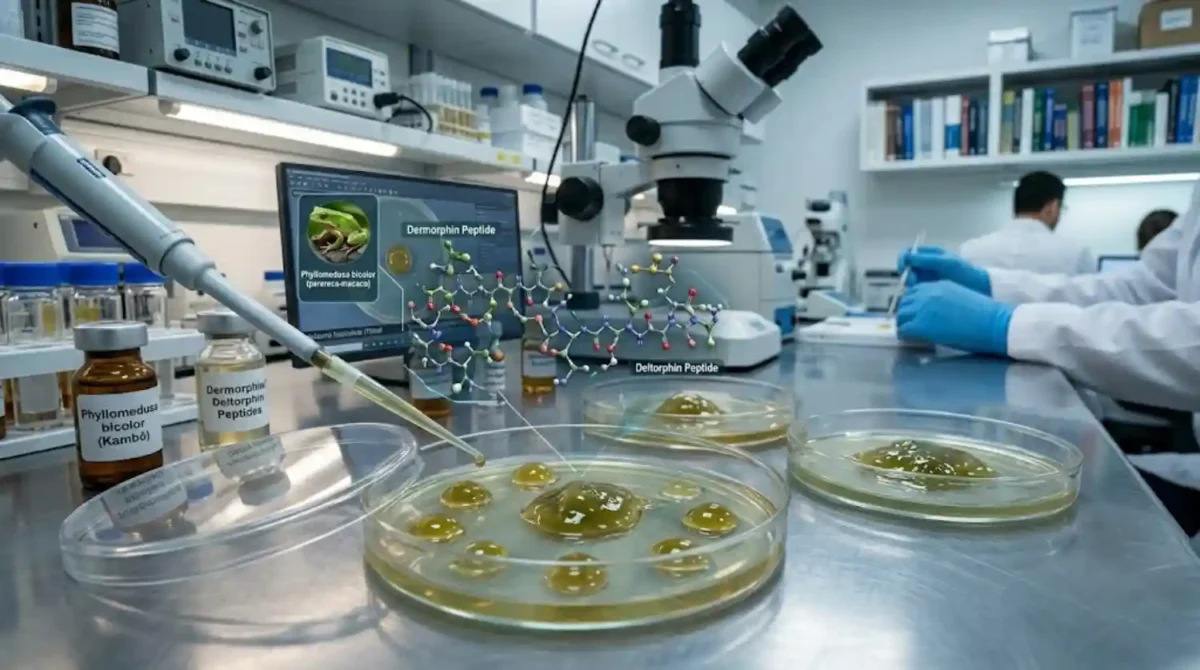
image 41

Uma molécula, mil possibilidades. Cientistas brasileiros e internacionais estão debruçados sobre a secreção cutânea da Phyllomedusa bicolor, conhecida popularmente como perereca-macaco ou “Kambô”. O que antes era restrito a rituais ancestrais de purificação está se revelando uma mina de ouro para a farmacologia moderna: o veneno de perereca amazônica para a saúde contém peptídeos capazes de atravessar a barreira hematoencefálica com efeitos antidepressivos potentes.
Os estudos, liderados por pesquisadores da UNB e do MPEG, focam em compostos específicos como a dermorfina e a deltorfina. Essas substâncias interagem com os receptores opioides do cérebro, mas de uma forma distinta da morfina tradicional, promovendo uma sensação de bem-estar e modulação emocional sem o alto risco de dependência química severa.
A busca por drogas naturais na Amazônia nunca foi tão intensa no campo da saúde mental. Com a crescente resistência aos tratamentos convencionais para depressão maior, os anfíbios como fonte de medicamentos representam uma fronteira biotecnológica que une o conhecimento milenar dos povos indígenas à biologia molecular.
Leia também
Como a clássica rota fluvial entre Belém e Marajó revela o intrigante universo dos búfalos nadadores nos campos alagados
Como a onça-pintada se tornou o único grande felino do planeta especialista em dominar répteis e rios na Amazônia
Como o turismo de vivência nos manguezais paraenses alia a preservação de caranguejos à sustentabilidade de comunidades costeirasO mecanismo de ação no sistema nervoso
Diferente dos antidepressivos comuns que levam semanas para alterar a química cerebral, os peptídeos extraídos da perereca amazônica apresentam uma resposta rápida. Eles atuam na modulação da dopamina e serotonina, os neurotransmissores do “prazer”, mas também possuem uma ação neuroprotetora, ajudando a regenerar conexões sinápticas danificadas pelo estresse crônico.
A secreção é composta por um coquetel complexo. Em laboratório, a ciência está isolando cada componente para eliminar os efeitos colaterais indesejados do veneno bruto — como náuseas e taquicardia — e potencializar apenas a fração que combate a anedonia (incapacidade de sentir prazer).
Estado da pesquisa farmacológica
Atualmente, a pesquisa está na fase de testes pré-clínicos avançados. O desafio é a síntese laboratorial: para que o tratamento se torne um medicamento de prateleira, não é necessário extrair o veneno diretamente do animal na natureza, mas sim replicar a molécula em ambiente controlado. Isso protege a biodiversidade e garante a padronização das doses.
Instituições como o Butantan e o Fiocruz acompanham de perto a regulamentação desses novos fármacos. O principal entrave é a biopirataria. A proteção do patrimônio genético amazônico é vital para que os benefícios econômicos dessas descobertas retornem para as comunidades detentoras do saber tradicional.
De acordo com dados do INPA, a Amazônia possui a maior diversidade de anfíbios do mundo, mas menos de 5% dessas espécies tiveram sua secreção analisada quimicamente. Cada perereca que desaparece devido ao desmatamento é, potencialmente, uma farmácia inteira que se fecha antes mesmo de ser inaugurada.
Anfíbios e a bioeconomia da saúde
A transformação do veneno em remédio é um pilar da bioeconomia. Em vez de vender a madeira, o valor reside na inteligência química da floresta viva. Relatórios do Imazon sugerem que o mercado de fármacos derivados da biodiversidade pode gerar bilhões para a região Norte, incentivando a conservação.

A depressão é considerada a “doença do século”, afetando milhões de pessoas no mundo. Se a solução para este mal global vier de um pequeno anfíbio verde das profundezas da selva, o mundo terá um motivo concreto e econômico para garantir que a Amazônia permaneça intocada.
A ciência está apenas começando a traduzir o idioma químico da floresta. O que os pajés chamavam de “ciência do Kambô”, os médicos agora chamam de neurofarmacologia de precisão. O futuro da saúde mental pode estar, literalmente, na palma da mão de uma pequena perereca amazônica.
Nunca perca uma notícia da AmazôniaControle o que você vê no Google
O Google lançou as Fontes Preferenciais: escolha os veículos que aparecem com prioridade. Adicione a Revista Amazônia e garanta cobertura exclusiva sempre em destaque.
Adicionar Revista Amazônia como Fonte Preferencial1. Pesquise qualquer assunto no Google
2. Toque no ⭐ ao lado de "Principais Notícias"
3. Busque Revista Amazônia e marque a caixa — pronto!
















Você precisa fazer login para comentar.